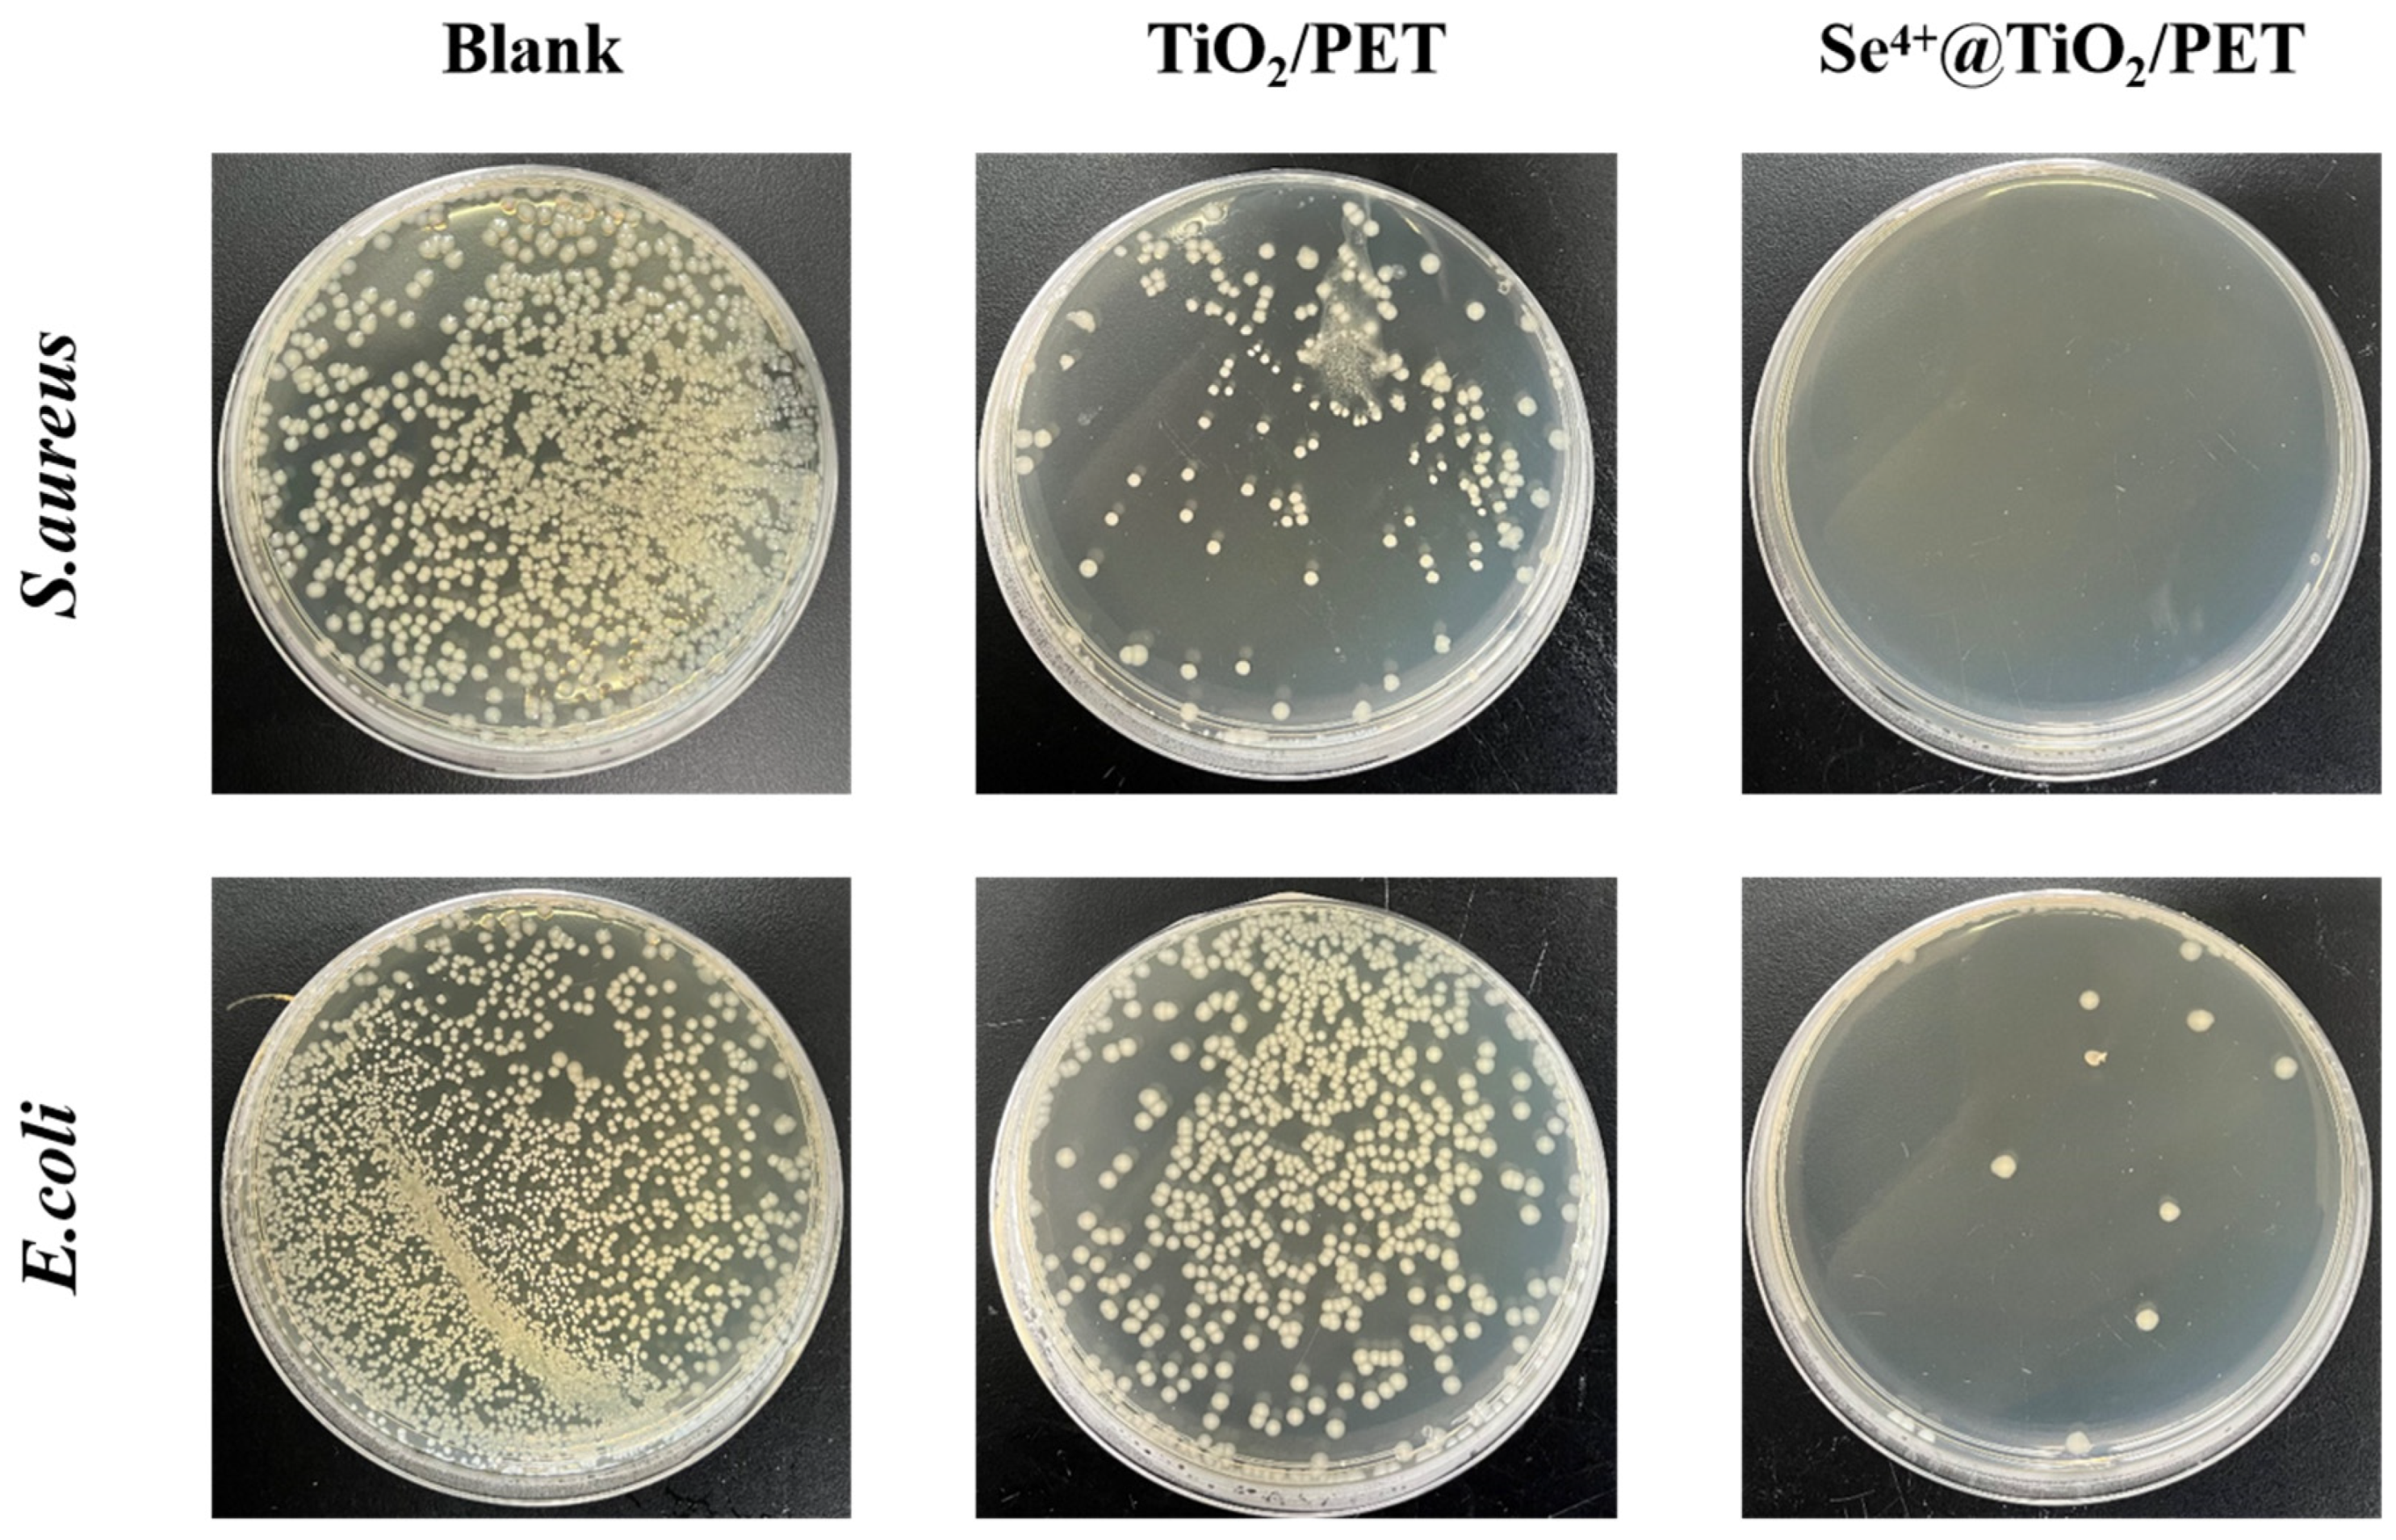
Molecules 30 01306 g011

Synthesis and Characterization of Se4+@TiO2/PET Composite Photocatalysts with Enhanced Photocatalytic Activity by Simulated Solar Irradiation and Antibacterial Properties
Abstract
1. Introduction
2. Results and Discussion
2.1. SEM Analyses
2.2. EDS Analyses
2.3. XRD Analyses
2.4. XPS Elemental Analysis
2.5. UV–Vis and PL Analyses
2.6. Photocatalytic Performance Analysis
2.7. EIS Analyses
2.8. Radical Scavenger Analysis
2.9. Antimicrobial Performance Analysis
2.10. The Photocatalytic Antibacterial Reaction Mechanism Analysis
3. Materials and Methods
3.1. Materials
3.2. Preparation of Se4+@TiO2 Composite Photocatalysts
3.3. Preparation of Se4+@TiO2-Loaded PET Fabrics
3.4. Characterization
3.5. Radical Trapping Analysis
3.6. Photocatalytic Degradation Performance Reaction Test
3.7. Evaluation of Antimicrobial Performance
4. Conclusions
Author Contributions
Funding
Institutional Review Board Statement
Informed Consent Statement
Data Availability Statement
Conflicts of Interest
References
- Niu, L.; Hu, Y.; Hu, H.; Zhang, X.; Wu, Y.; Giwa, A.S.; Huang, S. Kitchen-waste-derived biochar modified nanocomposites with improved photocatalytic performances for degrading organic contaminants. Environ. Res. 2022, 214, 114068. [Google Scholar] [CrossRef] [PubMed]
- Jarvin, M.; Rosaline, D.R.; Gopalakrishnan, T.; Kamalam, M.B.R.; Foletto, E.L.; Dotto, G.L.; Inbanathan, S.S.R. Remarkable photocatalytic performances towards pollutant degradation under sunlight and enhanced electrochemical properties of TiO2/polymer nanohybrids. Environ. Sci. Pollut. Res. 2023, 30, 62832–62846. [Google Scholar] [CrossRef] [PubMed]
- Liu, Y.; Xu, J.; Ding, Z.; Mao, M.; Li, L. Marigold shaped mesoporous composites Bi2S3/Ni(OH)2 with n-n heterojunction for high efficiency photocatalytic hydrogen production from water decomposition. Chem. Phys. Lett. 2021, 766, 138337. [Google Scholar] [CrossRef]
- Valverde-González, A.; López Calixto, C.G.; Barawi, M.; Gomez-Mendoza, M.; de la Peña O’Shea, V.A.; Liras, M.; Gómez-Lor, B.; Iglesias, M. Understanding charge transfer mechanism on effective truxene-based porous polymers–TiO2 hybrid photocatalysts for hydrogen evolution. ACS Appl. Energ. Mater. 2020, 3, 4411–4420. [Google Scholar] [CrossRef]
- Ma, Y.; Yi, X.; Wang, S.; Li, T.; Tan, B.; Chen, C.; Majima, T.; Waclawik, E.R.; Zhu, H.; Wang, J. Selective photocatalytic CO2 reduction in aerobic environment by microporous Pd-porphyrin-based polymers coated hollow TiO2. Nat. Commun. 2022, 13, 1400. [Google Scholar] [CrossRef]
- Li, N.; Chen, X.; Wang, J.; Liang, X.; Ma, L.; Jing, X.; Chen, D.-L.; Li, Z. ZnSe nanorods–CsSnCl3 perovskite heterojunction composite for photocatalytic CO2 reduction. ACS Nano 2022, 16, 3332–3340. [Google Scholar] [CrossRef] [PubMed]
- Yang, R.; Song, G.; Wang, L.; Yang, Z.; Zhang, J.; Zhang, X.; Wang, S.; Ding, L.; Ren, N.; Wang, A.; et al. Full solar-spectrum-driven antibacterial therapy over hierarchical Sn3O4/PDINH with enhanced photocatalytic activity. Small 2021, 17, 2102744. [Google Scholar] [CrossRef]
- Shi, L.; Ma, Z.; Qu, W.; Zhou, W.; Deng, Z.; Zhang, H. Hierarchical Z-scheme Bi2S3/CdS heterojunction: Controllable morphology and excellent photocatalytic antibacterial. Appl. Surf. Sci. 2021, 568, 150923. [Google Scholar] [CrossRef]
- Alamelu, K.; Raja, V.; Shiamala, L.; Jaffar Ali, B.M. Biphasic TiO2 nanoparticles decorated graphene nanosheets for visible light driven photocatalytic degradation of organic dyes. Appl. Surf. Sci. 2018, 430, 145–154. [Google Scholar] [CrossRef]
- Pant, B.; Park, M.; Park, S.-J. Recent Advances in TiO2 films prepared by sol-gel methods for photocatalytic degradation of organic pollutants and antibacterial activities. Coatings 2019, 9, 613. [Google Scholar] [CrossRef]
- Pant, B.; Pant, H.R.; Barakat, N.A.M.; Park, M.; Jeon, K.; Choi, Y.; Kim, H.-Y. Carbon nanofibers decorated with binary semiconductor (TiO2/ZnO) nanocomposites for the effective removal of organic pollutants and the enhancement of antibacterial activities. Ceram. Int. 2013, 39, 7029–7035. [Google Scholar] [CrossRef]
- Verma, V.; Al-Dossari, M.; Singh, J.; Rawat, M.; Kordy, M.G.M.; Shaban, M. A review on green synthesis of TiO2 NPs: Photocatalysis and antimicrobial applications. Polymers 2022, 14, 1444. [Google Scholar] [CrossRef] [PubMed]
- Pant, B.; Barakat, N.A.M.; Pant, H.R.; Park, M.; Saud, P.S.; Kim, J.-W.; Kim, H.-Y. Synthesis and photocatalytic activities of CdS/TiO2 nanoparticles supported on carbon nanofibers for high efficient adsorption and simultaneous decomposition of organic dyes. J. Colloid Interface Sci. 2014, 434, 159–166. [Google Scholar] [CrossRef]
- Ren, Y.; Zhao, Z.; Fan, T.; Luan, R.; Yao, L.; Shen, H.; Hu, X.; Cui, L.; Li, M.-X. Chitosan and TiO2 functionalized polypropylene nonwoven fabrics with visible light induced photocatalytic antibacterial performances. Int. J. Biol. Macromol. 2023, 250, 126305. [Google Scholar] [CrossRef] [PubMed]
- Pant, B.; Park, M.; Park, S.-J. Hydrothermal synthesis of Ag2CO3-TiO2 loaded reduced graphene oxide nanocomposites with highly efficient photocatalytic activity. Chem. Eng. Commun. 2019, 207, 688–695. [Google Scholar] [CrossRef]
- Dinh, C.T.; Yen, H.; Kleitz, F.; Do, T.O. Three-Dimensional ordered assembly of thin-shell Au/TiO2 hollow nanospheres for enhanced visible-light-driven photocatalysis. Angew. Chemie. Int. Ed. 2014, 53, 6618–6623. [Google Scholar] [CrossRef]
- Komaraiah, D.; Radha, E.; Sivakumar, J.; Reddy, M.V.R.; Sayanna, R. Influence of Fe3+ ion doping on the luminescence emission behavior and photocatalytic activity of Fe3+, Eu3+-codoped TiO2 thin films. J. Alloys Compd. 2021, 868, 159109. [Google Scholar] [CrossRef]
- Khan, H.; Swati, I.K. Fe3+-doped anatase TiO2 with d–d transition, oxygen vacancies and Ti3+ centers: Synthesis, characterization, UV–vis photocatalytic and mechanistic studies. Ind. Eng. Chem. Res. 2016, 55, 6619–6633. [Google Scholar] [CrossRef]
- Radha, E.; Komaraiah, D.; Sayanna, R.; Sivakumar, J. Photoluminescence and photocatalytic activity of rare earth ions doped anatase TiO2 thin films. J. Lumines. 2022, 244, 118727. [Google Scholar] [CrossRef]
- Tan, X.; Zhang, J.; Tan, D.; Shi, J.; Cheng, X.; Zhang, F.; Liu, L.; Zhang, B.; Su, Z.; Han, B. Ionic liquids produce heteroatom-doped Pt/TiO2 nanocrystals for efficient photocatalytic hydrogen production. Nano Res. 2019, 12, 1967–1972. [Google Scholar] [CrossRef]
- Stucchi, M.; Bianchi, C.L.; Argirusis, C.; Pifferi, V.; Neppolian, B.; Cerrato, G.; Boffito, D.C. Ultrasound assisted synthesis of Ag-decorated TiO2 active in visible light. Ultrason. Sonochem. 2018, 40, 282–288. [Google Scholar] [CrossRef] [PubMed]
- Liao, X.; Li, T.-T.; Ren, H.-T.; Mao, Z.; Zhang, X.; Lin, J.-H.; Lou, C.-W. Enhanced photocatalytic performance through the ferroelectric synergistic effect of p-n heterojunction BiFeO3/TiO2 under visible-light irradiation. Ceram. Int. 2021, 47, 10786–10795. [Google Scholar] [CrossRef]
- Pan, X.; Xu, Y.-J. Graphene-templated bottom-up fabrication of ultralarge binary CdS–TiO2 nanosheets for photocatalytic selective reduction. J. Phys. Chem. C 2015, 119, 7184–7194. [Google Scholar] [CrossRef]
- Yadav, H.M.; Kim, J.-S.; Pawar, S.H. Developments in photocatalytic antibacterial activity of nano TiO2: A review. Korean J. Chem. Eng. 2016, 33, 1989–1998. [Google Scholar] [CrossRef]
- Huang, F.; Yan, A.; Zhao, H. Influences of doping on photocatalytic properties of TiO2 photocatalyst. In Semiconductor Photocatalysis—Materials, Mechanisms and Applications; InTechOpen: Rijeka, Croatia, 2016. [Google Scholar] [CrossRef]
- Shi, J.; Chen, G.; Zeng, G.; Chen, A.; He, K.; Huang, Z.; Hu, L.; Zeng, J.; Wu, J.; Liu, W. Hydrothermal synthesis of graphene wrapped Fe-doped TiO2 nanospheres with high photocatalysis performance. Ceram. Int. 2018, 44, 7473–7480. [Google Scholar] [CrossRef]
- Zhu, J.; Chen, F.; Zhang, J.; Chen, H.; Anpo, M. Fe3+-TiO2 photocatalysts prepared by combining sol–gel method with hydrothermal treatment and their characterization. J. Photochem. Photobio. A Chem. 2006, 180, 196–204. [Google Scholar] [CrossRef]
- Zhou, Y.; Zhang, Q.; Shi, X.; Song, Q.; Zhou, C.; Jiang, D. Photocatalytic reduction of CO2 into CH4 over Ru-doped TiO2: Synergy of Ru and oxygen vacancies. J. Colloid Interface Sci. 2022, 608, 2809–2819. [Google Scholar] [CrossRef]
- Vidhya, R.; Malliga, P.; Karthikeyan, R.; Neyvasagam, K. Influence of nickel dopant concentration on structural, optical, magnetic and electrochemical properties of TiO2 nanoparticle. Int. J. Nanotechnol. 2021, 18, 610–621. [Google Scholar] [CrossRef]
- Xiang, H.; Tuo, B.; Tian, J.; Hu, K.; Wang, J.; Cheng, J.; Tang, Y. Preparation and photocatalytic properties of Bi-doped TiO2/montmorillonite composite. Opt. Mater. 2021, 117, 111137. [Google Scholar] [CrossRef]
- Zhang, D.; Chen, J.; Xiang, Q.; Li, Y.; Liu, M.; Liao, Y. Transition-metal-ion (Fe, Co, Cr, Mn, Etc.) doping of TiO2 nanotubes: A general approach. Inorg. Chem. 2019, 58, 12511–12515. [Google Scholar] [CrossRef]
- Mancuso, A.; Sacco, O.; Vaiano, V.; Sannino, D.; Pragliola, S.; Venditto, V.; Morante, N. Visible light active Fe-Pr co-doped TiO2 for water pollutants degradation. Catal. Today 2021, 380, 93–104. [Google Scholar] [CrossRef]
- Yalçın, Y.; Kılıç, M.; Çınar, Z. Fe+3-doped TiO2: A combined experimental and computational approach to the evaluation of visible light activity. Appl. Catal. B Environ. 2010, 99, 469–477. [Google Scholar] [CrossRef]
- Li, Y.; Ma, X.; Zhang, J.; Pan, X.; Li, N.; Chen, G.; Zhu, J. Degradable selenium-containing polymers for low cytotoxic antibacterial materials. ACS Macro Lett. 2022, 11, 1349–1354. [Google Scholar] [CrossRef]
- Huang, Y.; Chen, Q.; Zeng, H.; Yang, C.; Wang, G.; Zhou, L. A review of selenium (Se) nanoparticles: From synthesis to applications. Part. Part. Syst. Charact. 2023, 40, 2300098. [Google Scholar] [CrossRef]
- Cheng, H.; Zhang, M.; Hu, H.; Gong, Z.; Zeng, Y.; Chen, J.; Zhu, Z.; Wan, Y. Selenium-modified TiO2 nanoarrays with antibacterial and anticancer properties for postoperation therapy applications. ACS Appl. Bio Mater. 2018, 1, 1656–1666. [Google Scholar] [CrossRef]
- Lin, Z.H.; Roy, P.; Shih, Z.Y.; Ou, C.M.; Chang, H.T. Synthesis of anatase Se/Te-TiO2 nanorods with dominant {100} facets: Photocatalytic and antibacterial activity induced by visible light. ChemPlusChem 2013, 78, 302–309. [Google Scholar] [CrossRef]
- Gurkan, Y.Y.; Kasapbasi, E.; Cinar, Z. Enhanced solar photocatalytic activity of TiO2 by selenium(IV) ion-doping: Characterization and DFT modeling of the surface. Chem. Eng. J. 2013, 214, 34–44. [Google Scholar] [CrossRef]
- Xie, W.; Li, R.; Xu, Q. Enhanced photocatalytic activity of Se-doped TiO2 under visible light irradiation. Sci. Rep. 2018, 8, 8752. [Google Scholar] [CrossRef]
- Magnone, E.; Kim, M.K.; Lee, H.J.; Park, J.H. Facile synthesis of TiO2-supported Al2O3 ceramic hollow fiber substrates with extremely high photocatalytic activity and reusability. Ceram. Int. 2021, 47, 7764–7775. [Google Scholar] [CrossRef]
- Rashid, M.M.; Simončič, B.; Tomšič, B. Recent advances in TiO2-functionalized textile surfaces. Surf. Interfaces 2021, 22, 100890. [Google Scholar] [CrossRef]
- Wang, Q.; Li, J.; Bai, Y.; Lu, X.; Ding, Y.; Yin, S.; Huang, H.; Ma, H.; Wang, F.; Su, B. Photodegradation of textile dye Rhodamine B over a novel biopolymer–metal complex wool-Pd/CdS photocatalysts under visible light irradiation. J. Photochem. Photobiol. B Biol. 2013, 126, 47–54. [Google Scholar] [CrossRef] [PubMed]
- D’Amato, C.; Giovannetti, R.; Zannotti, M.; Rommozzi, E.; Minicucci, M.; Gunnella, R.; Di Cicco, A. Band gap implications on nano-TiO2 surface modification with ascorbic acid for visible light-active polypropylene coated photocatalyst. Nanomaterials 2018, 8, 599. [Google Scholar] [CrossRef] [PubMed]
- Min, K.S.; Manivannan, R.; Son, Y.-A. Porphyrin Dye/TiO2 imbedded PET to improve visible-light photocatalytic activity and organosilicon attachment to enrich hydrophobicity to attain an efficient self-cleaning material. Dyes Pigm. 2019, 162, 8–17. [Google Scholar] [CrossRef]
- Alotaibi, A.M.; Williamson, B.A.D.; Sathasivam, S.; Kafizas, A.; Alqahtani, M.; Sotelo-Vazquez, C.; Buckeridge, J.; Wu, J.; Nair, S.P.; Scanlon, D.O.; et al. Enhanced photocatalytic and antibacterial ability of Cu-doped anatase TiO2 thin films: Theory and experiment. ACS Appl. Mater. Interfaces 2020, 12, 15348–15361. [Google Scholar] [CrossRef]
- Khan, H.; Berk, D. Selenium modified oxalate chelated titania: Characterization, mechanistic and photocatalytic studies. Appl. Catal. A Gen. 2015, 505, 285–301. [Google Scholar] [CrossRef]
- Ahmad, D.; Manzoor, M.Z.; Kousar, R.; Somaily, H.H.; Buzdar, S.A.; Ullah, H.; Nazir, A.; Warsi, M.F.; Batool, Z. Cost effective synthesis of CuxBi2-xSe3 photocatalysts by sol-gel method and their enhanced photodegradation and antibacterial activities. Ceram. Int. 2022, 48, 32787–32797. [Google Scholar] [CrossRef]
- Wu, C.; Corrigan, N.; Lim, C.-H.; Jung, K.; Zhu, J.; Miyake, G.; Xu, J.; Boyer, C. Guiding the design of organic photocatalyst for PET-RAFT polymerization: Halogenated xanthene dyes. Macromolecules 2018, 52, 236–248. [Google Scholar] [CrossRef]
- Huang, J.; Dou, L.; Li, J.; Zhong, J.; Li, M.; Wang, T. Excellent visible light responsive photocatalytic behavior of N-doped TiO2 toward decontamination of organic pollutants. J. Hazard. Mater. 2021, 403, 123857. [Google Scholar] [CrossRef]
- Wu, T.; Zhao, H.; Zhu, X.; Xing, Z.; Liu, Q.; Liu, T.; Gao, S.; Lu, S.; Chen, G.; Asiri, A.M.; et al. Identifying the origin of Ti3+ activity toward enhanced electrocatalytic N2 reduction over TiO2 nanoparticles modulated by mixed-valent copper. Adv. Mater. 2020, 32, e2000299. [Google Scholar] [CrossRef]
- Wu, S.X.; Ma, Z.; Qin, Y.N.; He, F.; Jia, L.S.; Zhang, Y.J. XPS study of copper doping TiO2 photocatalyst. Acta Phys.-Chim. Sin. 2003, 19, 967–969. [Google Scholar] [CrossRef]
- Mangayayam, M.; Kiwi, J.; Giannakis, S.; Pulgarin, C.; Zivkovic, I.; Magrez, A.; Rtimi, S. FeOx magnetization enhancing E. coli inactivation by orders of magnitude on Ag-TiO2 nanotubes under sunlight. Appl. Catal. B Environ. 2017, 202, 438–445. [Google Scholar] [CrossRef]
- Shan, C.; Su, Z.; Liu, Z.; Xu, R.; Wen, J.; Hu, G.; Tang, T.; Fang, Z.; Jiang, L.; Li, M. One-step synthesis of Ag2O/Fe3O4 magnetic photocatalyst for efficient organic pollutant removal via wide-spectral-response photocatalysis–fenton coupling. Molecules 2023, 28, 4155. [Google Scholar] [CrossRef]
- Rao, Z.; Shi, G.; Wang, Z.; Mahmood, A.; Xie, X.; Sun, J. Photocatalytic degradation of gaseous VOCs over Tm3+-TiO2: Revealing the activity enhancement mechanism and different reaction paths. Chem. Eng. J. 2020, 395, 125078. [Google Scholar] [CrossRef]
- Murugesan, R.; Sivakumar, S.; Karthik, K.; Anandan, P.; Haris, M. Structural, optical and magnetic behaviors of Fe/Mn-doped and co-doped CdS thin films prepared by spray pyrolysis method. Appl. Phy. A 2019, 125, 281. [Google Scholar] [CrossRef]
- Zhang, H.Y.; Yu, H.; Dai, J.D.; Huang, X.Y.; Liu, C.M. Microstructure, photoluminescence and photocatalytic activity of ZnO-MoS2-TiO2 composite. Chin. J. Phys. 2018, 56, 3053–3061. [Google Scholar] [CrossRef]
- Kansal, S.K.; Lamba, R.; Mehta, S.K.; Umar, A. Photocatalytic degradation of Alizarin Red S using simply synthesized ZnO nanoparticles. Mater. Lett. 2013, 106, 385–389. [Google Scholar] [CrossRef]
- Kibombo, H.S.; Weber, A.S.; Wu, C.-M.; Raghupathi, K.R.; Koodali, R.T. Effectively dispersed europium oxide dopants in TiO2 aerogel supports for enhanced photocatalytic pollutant degradation. J. Photochem. Photobio. A Chem. 2013, 269, 49–58. [Google Scholar] [CrossRef]
- Qureshi, A.A.; Javed, H.M.A.; Javed, S.; Bashir, A.; Usman, M.; Akram, A.; Ahmad, M.I.; Ali, U.; Shahid, M.; Rizwan, M.; et al. Incorporation of Zr-doped TiO2 nanoparticles in electron transport layer for efficient planar perovskite solar cells. Surf. Interfaces 2021, 25, 101299. [Google Scholar] [CrossRef]
- Pattanayak, D.S.; Mishra, J.; Nanda, J.; Sahoo, P.K.; Kumar, R.; Sahoo, N.K. Photocatalytic degradation of cyanide using polyurethane foam immobilized Fe-TCPP-S-TiO2-rGO nano-composite. J. Environ. Manag. 2021, 297, 113312. [Google Scholar] [CrossRef]
- Enesca, A.; Isac, L. Tandem structures semiconductors based on TiO2_SnO2 and ZnO_SnO2 for photocatalytic organic pollutant removal. Nanomaterials 2021, 11, 200. [Google Scholar] [CrossRef]
- Chang, F.; Li, J.; Kou, Y.; Bao, W.; Shi, Z.; Zhu, G.; Kong, Y. The intense charge migration and efficient photocatalytic NO removal of the S-scheme heterojunction composites Bi7O9I3-BiOBr. Sep. Purif. Technol. 2025, 353, 128402. [Google Scholar] [CrossRef]
- Bai, Y.; Hu, X.; Tian, T.; Cai, B.; Li, Y. Carbon pre-protected iron strategy to construct Fe, C-codoped g-C3N4 for effective photodegradation of organic pollutants via hole oxidation mechanism. J. Cleaner Prod. 2024, 437, 140739. [Google Scholar] [CrossRef]
- Henriksen-Lacey, M.; Carregal-Romero, S.; Liz-Marzán, L.M. Current Challenges toward In vitro cellular validation of inorganic nanoparticles. Bioconjugate Chem. 2016, 28, 212–221. [Google Scholar] [CrossRef]
- Horie, M.; Sugino, S.; Kato, H.; Tabei, Y.; Nakamura, A.; Yoshida, Y. Does photocatalytic activity of TiO2 nanoparticles correspond to photo-cytotoxicity? Cellular uptake of TiO2 nanoparticles is important in their photo-cytotoxicity. Toxicol. Mech. Methods 2016, 26, 284–294. [Google Scholar] [CrossRef]
- Zhu, Z.; Cai, H.; Sun, D.W.; Wang, H.W. Photocatalytic effects on the quality of pork packed in the package combined with TiO2 coated nonwoven fabrics. J. Food Process Eng. 2019, 42, e12993. [Google Scholar] [CrossRef]
- Wang, W.; Li, G.; Xia, D.; An, T.; Zhao, H.; Wong, P.K. Photocatalytic nanomaterials for solar-driven bacterial inactivation: Recent progress and challenges. Environ. Sci.-Nano 2017, 4, 782–799. [Google Scholar] [CrossRef]
- Bozzi, A.; Yuranova, T.; Guasaquillo, I.; Laub, D.; Kiwi, J. Self-cleaning of modified cotton textiles by TiO2 at low temperatures under daylight irradiation. J. Photochem. Photobiol. A Chem. 2005, 174, 156–164. [Google Scholar] [CrossRef]
- Wang, G.; Cheng, H. Application of photocatalysis and sonocatalysis for treatment of organic dye wastewater and the synergistic effect of ultrasound and light. Molecules 2023, 28, 3706. [Google Scholar] [CrossRef] [PubMed]
- Guo, Q.; Zhou, C.; Ma, Z.; Yang, X. Fundamentals of TiO2 photocatalysis: Concepts, mechanisms, and challenges. Adv. Mater. 2019, 31, 1901997. [Google Scholar] [CrossRef]
- Wang, C.-Y.; Böttcher, C.; Bahnemann, D.W.; Dohrmann, J.K. A comparative study of nanometer sized Fe(iii)-doped TiO2photocatalysts: Synthesis, characterization and activity. J. Mater. Chem. 2003, 13, 2322–2329. [Google Scholar] [CrossRef]
- Amiri, M.R.; Alavi, M.; Taran, M.; Kahrizi, D. Antibacterial, antifungal, antiviral, and photocatalytic activities of TiO2 nanoparticles, nanocomposites, and bio-nanocomposites: Recent advances and challenges. J. Public Health Res. 2022, 11, 22799036221104151. [Google Scholar] [CrossRef]
- Uyguner Demirel, C.S.; Birben, N.C.; Bekbolet, M. A comprehensive review on the use of second generation TiO2 photocatalysts: Microorganism inactivation. Chemosphere 2018, 211, 420–448. [Google Scholar] [CrossRef]
- Zhang, T.; Qi, M.; Wu, Q.; Xiang, P.; Tang, D.; Li, Q. Recent research progress on the synthesis and biological effects of selenium nanoparticles. Front. Nutr. 2023, 10, 1183487. [Google Scholar] [CrossRef]
- Raksha, K.R.; Ananda, S.; Madegowda, N.M. Study of kinetics of photocatalysis, bacterial inactivation and • OH scavenging activity of electrochemically synthesized Se4+ doped ZnS nanoparticles. J. Mol. Catal. A Chem. 2015, 396, 319–327. [Google Scholar] [CrossRef]
- RokickA Konieczna, P.; Morawski, A.W. Photocatalytic bacterial destruction and mineralization by TiO2-based photocatalysts: A mini review. Molecules 2024, 29, 2221. [Google Scholar] [CrossRef] [PubMed]
- Dariani, R.S.; Esmaeili, A.; Mortezaali, A.; Dehghanpour, S. Photocatalytic reaction and degradation of methylene blue on TiO2 nano-sized particles. Optik 2016, 127, 7143–7154. [Google Scholar] [CrossRef]
- GB/T 20944.3-2008; Textiles—Evaluation for Antibacterial Activity—Part 3: Shake Flask Method. China National Standards: Beijing, China, 2008.
- Zhang, G.; Wang, D.; Yan, J.; Xiao, Y.; Gu, W.; Zang, C. Study on the photocatalytic and antibacterial properties of TiO2 nanoparticles-coated cotton fabrics. Materials 2019, 12, 2010. [Google Scholar] [CrossRef]
- Wang, Q.; Liu, S.; Lu, W.; Zhang, P. Fabrication of curcumin@Ag loaded core/shell nanofiber membrane and its synergistic antibacterial properties. Front. Chem. 2022, 10, 870666. [Google Scholar] [CrossRef]

| Samples | Kapp | R2 |
|---|---|---|
| MO | 0.0007 | 0.98443 |
| PET | 0.0014 | 0.99331 |
| TiO2/PET | 0.00227 | 0.99609 |
| Se4+@TiO2/PET | 0.0101 | 0.97474 |
| Radical Scavenger | Blank | IPA | BQ | EDTA-2Na |
|---|---|---|---|---|
| Degradation efficiency % | 81 | 77.28 | 47.11 | 72.64 |
| Samples | Concentration of Live E. coli Bacteria/(CFU·mL−1) | Inhibition Rate (%) | Concentration of Live S. aureus Bacteria/ (CFU·mL−1) | Inhibition Rate (%) |
|---|---|---|---|---|
| Blank | 9.2 × 105 | n/a | 8.9 × 105 | n/a |
| TiO2/PET | 3.86 × 105 | 58.04 | 1.04 × 105 | 88.31 |
| Se4+@TiO2/PET | 1.4 × 104 | 98.47 | 0 | 99.99 |
Disclaimer/Publisher’s Note: The statements, opinions and data contained in all publications are solely those of the individual author(s) and contributor(s) and not of MDPI and/or the editor(s). MDPI and/or the editor(s) disclaim responsibility for any injury to people or property resulting from any ideas, methods, instructions or products referred to in the content. |
© 2025 by the authors. Licensee MDPI, Basel, Switzerland. This article is an open access article distributed under the terms and conditions of the Creative Commons Attribution (CC BY) license (https://creativecommons.org/licenses/by/4.0/).
Share and Cite
Ren, Y.; Luan, R.; Zhao, Z.; Tang, L.; Wang, C.; Li, Y.; Li, M. Synthesis and Characterization of Se4+@TiO2/PET Composite Photocatalysts with Enhanced Photocatalytic Activity by Simulated Solar Irradiation and Antibacterial Properties. Molecules 2025, 30, 1306. https://doi.org/10.3390/molecules30061306
Ren Y, Luan R, Zhao Z, Tang L, Wang C, Li Y, Li M. Synthesis and Characterization of Se4+@TiO2/PET Composite Photocatalysts with Enhanced Photocatalytic Activity by Simulated Solar Irradiation and Antibacterial Properties. Molecules. 2025; 30(6):1306. https://doi.org/10.3390/molecules30061306
Chicago/Turabian StyleRen, Yu, Rui Luan, Ziyao Zhao, Lina Tang, Chunxia Wang, Yuehui Li, and Meixian Li. 2025. "Synthesis and Characterization of Se4+@TiO2/PET Composite Photocatalysts with Enhanced Photocatalytic Activity by Simulated Solar Irradiation and Antibacterial Properties" Molecules 30, no. 6: 1306. https://doi.org/10.3390/molecules30061306
APA StyleRen, Y., Luan, R., Zhao, Z., Tang, L., Wang, C., Li, Y., & Li, M. (2025). Synthesis and Characterization of Se4+@TiO2/PET Composite Photocatalysts with Enhanced Photocatalytic Activity by Simulated Solar Irradiation and Antibacterial Properties. Molecules, 30(6), 1306. https://doi.org/10.3390/molecules30061306





